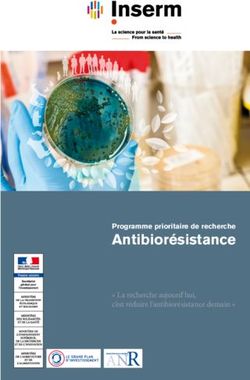
Antibiorésistance " La recherche aujourd'hui, c'est réduire l'antibiorésistance demain " - Inserm

Actes du colloque de Nîmes - IUT
←
→
Transcription du contenu de la page
Si votre navigateur ne rend pas la page correctement, lisez s'il vous plaît le contenu de la page ci-dessous
N°92 // DÉCEMBRE 2018 // 37 e ANNÉE
Actes du colloque
de Nîmes
NÎMES - Maison carrée
R E V U E D E S D É PA R T E M E N T S D E G É N I E É L E C T R I Q U E & I N F O R M AT I Q U E I N D U S T R I E L L E2 // ACTES DU COLLOQUE DE NÎMES
édito https://gesi.iut.fr/
Nîmes
30-31 mai
et 1er juin 2018
Consultez le site du Gesi :
Nîmes
Pour tout savoir sur l'histoire de GeSi, consulter le site :
https://gesi.iut.fr/
Merci à l'équipe de Brive pour ce beau travail.
Chers amis, chers collègues,
Toute l'équipe d'organisation du colloque Nîmois vous présente ses meilleurs voeux pour cette année 2019.
Alors oui, je vous confirme aujourd'hui que l'organisation d'un tel colloque n'est pas une mince affaire !
Mais lorsque les retours sont positifs comme ils l'ont été, toute cette fatigue s'envole. J'espère que
vous avez tous pu profiter de notre ville et surtout de nos trois commissions. Ce colloque fut très
orienté industrie, à tel point qu'il y avait des industriels pendant les plénières et dans toutes les
commissions. Cette décision a beaucoup plu à ces derniers qui ne demandent qu'à participer à cet
événement afin de nous montrer ce qu'il se passe dans l'industrie.
Je dois remercier pour cela les organisateurs de ces commissions : je pense à Jean-Pierre Lenormand, Thierry Glaisner
et David Glay pour l'industrie du futur. Cette commission aurait pu durer 4 jours tant le nombre de participants augmentait
à l'approche du colloque. Quel bonheur de travailler avec ces trois-là ! Laurent Laval et son énergie débordante, Florent
Bruguier et Joël Durand (même les Nîmois étaient mis à contribution) pour la commission cybersécurité. Marouane
Alma et Alain Tinel, qui ont dû contenir quelques conférenciers un peu long... pour la commission énergie et efficacité
énergétique. Merci bien sûr à vous tous d'être venus voir le soleil qui est finalement apparu le dernier jour. Merci pour
votre bonne humeur, ces moments de convivialité et cette belle ambiance.
Merci enfin à toute l'équipe organisatrice, personnels du département et personnels de l'IUT qui ont travaillé d'arrache
pied pour la réussite de ce moment important pour les départements GEII.
C'est donc tout à fait détendu et serein que je passe le relais (l'enclume) à mon ami Marouane Alma et l'IUT de Longwy.
Quel bonheur d'aller participer à un colloque organisé ailleurs !
Le département GEII de Longwy est déjà très investi dans l'organisation et je ne doute pas qu'ils nous offriront à tous un
très beau et très intéressant Colloque.
Nîmes 2018, 45e colloque pédagogique national a bien vécu vive Longwy 2019.
Patrick Effantin et toute l'équipe organisatrice du département GEII de Nî mes
Revue des départements Génie Électrique & Informatique Industrielle des Instituts Universitaires de Technologie
Directeur de la publication : Philippe Lavallée - Responsable du comité de rédaction : Gino Gramaccia - gino.gramaccia@u-bordeaux.fr
Comptabilité : Monique Thomas
Comité de rédaction : Christian Pécoste - IUT Bordeaux, Florence Hénon IUT de Chartres
Impression : Imprimerie Laplante - 3, impasse Jules Hetzel - 33700 Mérignac - Téléphone : 05 56 97 15 05 - e-mail : pao@laplante.fr
Crédit photos : GettyImages - Dépôt légal : Décembre 2018 - ISSN : 1156-0681
GESI // 37 e ANNÉEN°92 // DÉCEMBRE 2018 // ACTES DU COLLOQUE DE NÎMES / 3
sommaire
• Édito de Patrick EFFANTIN p2
ACTES DU COLLOQUE DE NÎMES
• Commission 1 : Cyber-sécurité p4
Laurent LAVAL (IUT de Villetaneuse)
• Commission 2 : Énergie et efficacité énergétique p8
Marouane ALMA (IUT de Longwy) / Alain TINEL (IUT du Havre)
• Commission 3 : Systèmes technologiques de l'Industrie du Futur p 12
Thierry GLAISNER (IUT de Ville d’Avray) / David GLAY (IUT de Lille)
Jean-Pierre LE NORMAND (IUT de Haguenau)
• Retour en images sur le Colloque de Nîmes p 16
SCIENCES & TECHNOLOGIES
• CyberEdu à la Commission 1 Cybersécurité p 17
Philippe WERLE (Vice-Président Outils de CyberEdu et Responsable du Management
de la Sécurité des Systèmes d’Information de l’Université de Bordeaux)
• Localisation et identification de ressources industrielles par l'Internet des objets p 19
Eddy BAJIC (IUT Nancy Brabois)
HORIZON SCIENCES HUMAINES
• Le DUT GEII par apprentissage à l’IUT de Nancy-Brabois p 28
Franck Joly (IUT Nancy-Brabois)
• Projets tuteurés : une opportunité pour tisser du lien socio-économique p 31
Taha BOUKHOBZA (IUT Nancy-Brabois, Université de Lorraine)
Denis CRONEL (Centre interarmées de la solde, Défense Nationale)
Cédric JOIN (IUT Nancy-Brabois, Université de Lorraine)
Christophe SIMON (IUT Nancy-Brabois, Université de Lorraine)
ERRATUM
Page 4 du GeSi n°91, il fallait lire : Autour du colloque de Nîmes, et non Actes du colloque du Calais. Toutes nos excuses.
RE V U E DE S DÉ PA RT E ME NT S D E GÉ N I E É L E C TR I QU E & I N F OR MATI QU E I N D USTRIELLE4 // ACTES DU COLLOQUE DE NÎMES
ACTES DU COLLOQUE DE NÎMES
Commission 1
Cybersécurité
Laurent LAVAL (IUT de Villetaneuse)
Préambule objets connectés, en passant par des automatismes de production
et les systèmes embarqués) et, plus inquiétant encore, en termes
Dans un passé encore récent, pour une grande partie de de cibles humaines (de l’individu lambda jusqu’au dirigeant d’un
la population, les attaques des systèmes informatiques et pays, en passant par des groupes de population). De récentes
de communication étaient généralement assimilées à des études, également diffusées à grande échelle par les médias, ont
épiphénomènes sporadiques et aux impacts essentiellement également contribué à sensibiliser la population à la très forte
limités à la corruption de données (effacement, altération), leur augmentation de ces activités malveillantes - en quelques chiffres
divulgation non consentie, des pertes d’accès à des services : onze fois plus de logiciels malveillants (vers, virus, malware...)
ou à des fonctionnalités (logicielles ou matérielles) et surtout du circulaient en 2017 sur internet qu’en 2016, 57 % des entreprises
temps passé à opérer une maintenance curative des systèmes ont déclaré avoir été victimes d’une cyberattaque en 2016 contre
attaqués (incluant la récupération de données). Ces attaques 32 % en 2015, CISCO évoque une augmentation de 268 %,
apparaissaient souvent comme l’œuvre de script-kiddies en depuis novembre 2016, du trafic d’éléments malveillants via des
quête d’expériences transgressives ou de hackers isolés à la communications chiffrées (elles-mêmes en augmentation), +83
recherche d’exploits pour exhiber leurs compétences aux yeux de % de smartphones infectés au 2ème semestre 2016 par rapport
microcosmes d’initiés (Black Hats, Grey Hats…). Les principales au 1er semestre (source : Nokia), etc. Enfin, les médias (incluant
motivations alors recensées étaient le challenge individuel les sites d’informations spécialisés ou non) ont également mis
(satisfaction personnelle ou comparaison avec autrui), le besoin en évidence l’existence de forces de frappe considérables2,
de reconnaissance ou de notoriété (même dissimulée derrière un déployées par des groupes de cybercriminels organisés, de
pseudonyme), l’envie de transgresser les interdits, etc. Dans tous plus en plus nombreux et aptes à mener des (cyber)attaques
ces contextes, les échelles de valeurs étaient essentiellement : complexes et/ou de grandes ampleurs.
le niveau de technicité déployé pour découvrir ou exploiter une
Le plus inquiétant est toutefois de constater que la principale
faille de sécurité, ou encore la capacité de nuisance (qu’elle soit
motivation des pirates informatiques est devenue économique en
potentielle et non totalement mise en œuvre comme chez les
orientant leurs activités malveillantes vers la récupération illicite
Grey Hats / White Hats ou effective et exercée comme chez les
de données personnelles valorisables et surtout des extorsions
Black Hats). Dans ce proche passé, la dimension économique
de fonds à partir de ransomwares (rançongiciels en Français) ou
des actes de malveillance paraissait également circonscrite
de mails d’intimidation. En quelques chiffres : les ransomware
aux actions des phreakers (désireux d’exploiter les réseaux
ont enregistré une augmentation de 36 % entre 2016 et 2017
téléphoniques sans payer), à des opérations ciblées à l’encontre
et l'entreprise Symantec, spécialisée dans les antivirus et la
de certaines entreprises (blocage temporaire du fonctionnement,
sécurité informatique, annonçait avoir bloqué près de 320 000
détournement d’informations...), en passant par l’utilisation
ransomware au premier semestre 2017 (source : FIGARO, 5
frauduleuse et/ou illicite de matériels personnels (cartes bleues,
septembre 2017).
ressources des ordinateurs...). Or, suite à la multiplication
d’évènements relatés dans les médias (Affaire « Stuxnet », Même si les institutions et les entreprises demeurent des cibles
piratage du téléphone et du PC de la Chancelière allemande, importantes (En France, 80 % des PME ont été victimes de
piratage de comptes Instagram de personnalités, prise de cyberattaques : du ransomware (61 %) au déni de service (38 %)
contrôle à distance de calculateurs de voitures...), la perception en passant par la défiguration de site web (23 %) ou encore le vol
de la cybercriminalité1 semble avoir évolué. Les périmètres de données personnelles (18 %)), l’attention des cybercriminels,
des activités malveillantes et/ou frauduleuses à base d’outils motivés par les enjeux économiques, se concentre de plus
informatiques apparaissent désormais, aux yeux du grand public, en plus sur des cibles à la fois plus nombreuses, accessibles
sans limites en termes de cibles matérielles (de l’ordinateur aux et vulnérables que sont les individus lambda. Tout ceci repose
1 Cf. https://www.kaspersky.fr/resource-center/threats/cybercrime
2 au sens de la capacité à mettre à mal la sécurité d’un système informatique ou d’un réseau.
GESI // 37 e ANNÉEN°92 // DÉCEMBRE 2018 // ACTES DU COLLOQUE DE NÎMES / 5
naturellement sur l’essor des systèmes informatisés en tous insouciance, appât de la gratuité et même son aptitude à être
genres (ordinateurs, téléphones, tablettes, calculateurs, apeuré) qui sont largement exploitées par les cybercriminels
systèmes embarqués...) et de leur connectivité. Nous sommes par du phishing, du téléchargement gratuit piégé ou autres. De
ainsi passés, en très peu de temps et sans réel accompagnement fait, le développement et l’efficacité de la sécurité informatique
de la population, du concept de l’informatique pour tout le monde impliquent nécessairement une éducation des utilisateurs et
à l’informatique ubiquitaire / omniprésente / pervasive : « Accès des concepteurs à grande échelle, tant pour l’acquisition de
à l’information pour tout le monde, n’importe où et n’importe connaissances sur les risques que pour l’adoption de bonnes
quand ». Il est alors aisé de comprendre que la multiplication des pratiques (mise en place de protections) / bons réflexes face aux
systèmes connectés et notre méconnaissance individuelle de attaques.
leur technologie accroissent notre vulnérabilité. S’il est possible
de déployer des solutions techniques pour se protéger plus ou
moins efficacement, la principale faille de sécurité reste l’individu
Les certificats (définition, rôle, utilité,
en lui-même par sa méconnaissance des risques (actions qui le mise en œuvre …)
mettent en danger) et des procédures pour les limiter. L’objectif Intervenant : Philippe WERLE - Vice-Président Outils
de cette commission était ainsi de sensibiliser les participants, CyberEdu - Responsable du Management de la Sécurité des
de manière accessible à tous, aux problèmes et enjeux liés à Systèmes d'Information (Université de Bordeaux)
la sécurité informatique au sens large. Dans ce cadre, des
intervenants industriels des entreprises CISCO et Schneider L’utilisation d’Internet est omniprésente dans notre quotidien
Electric ont apporté leur connaissance et leur vision de la pour la consultation/mise à jour directe ou indirecte de bases de
problématique de sécurité dans les réseaux de communication et données (saisie à distance de notes d’étudiants, consultation des
les systèmes automatisés. Ces interventions ont été complétées comptes bancaires, achats en ligne...). Or, trop peu d’utilisateurs
par un ensemble d’exposés et de démonstrations visant, à travers se posent des questions telles que : Est-ce que le serveur auquel
un subtil équilibre entre vulgarisation technique et technicité, à je me connecte en cliquant sur un lien est le véritable serveur
balayer un spectre étendu d’attaques, de vulnérabilités et de souhaité (et non pas un serveur mis en place par un pirate
cibles : du logiciel à l’être humain en passant par le matériel informatique pour leurrer les utilisateurs) ? Est-ce que le cadenas
jusqu’aux composants électroniques. Les sections suivantes qui apparait à gauche de l’URL3 ou le « s » qui vient compléter le
tentent de résumer ces différentes interventions. nom du protocole HTTP (pour donner https) suffisent à garantir
l’authenticité4 du serveur contacté ?
Ainsi, comme expliqué et mis en évidence au travers de
démonstrations par Philippe WERLE, Vice-Président Outils
Principales vulnérabilités CyberEdu, des réponses aux questions précédentes reposent sur
et principales techniques l’utilisation des certificats électroniques ou certificats numériques
(sortes de carte d’identité numérique pour l’authentification) que
d’attaques (logicielles) les serveurs « présentent » aux navigateurs des postes clients
Intervenant : Yassin EL HILLALI - IUT de Valenciennes comme preuve de leur identité. Malheureusement, de nombreux
administrateurs de sites web (universités, enseignes d’e-
Après un recensement des principales motivations des auteurs commerce, associations…) n’utilisent pas des certificats émis et
d’attaques (challenge, jeu, transgression des interdits...), de leurs vérifiés par une Autorité de Certification. En effet, pour des raisons
conséquences techniques (fuite de données, augmentation de purement économiques, certains administrateurs sont tentés
privilèges, vandalisme...) et économiques (perte de revenu, frais d’utiliser des certificats SSL auto-signés : certificats gratuits,
de maintenance préventive et curative...), cet exposé a présenté créés et gérés par l’administrateur. La plupart des navigateurs
quelques exemples concrets de procédures d’attaques : du Cyber déclenchent des alertes de sécurité (messages ou pop-up)
classique Deny of Service (DoS) susceptible de bloquer le face aux certificats auto-signés. Malheureusement, un simple clic
fonctionnement de serveurs, à l’injection de code aboutissant par l’utilisateur (sans même lire le message…) permet de passer
à une intrusion dans un système informatique. Cet exposé outre ces alertes et de continuer la navigation. Ceci constitue
a notamment permis de mettre en évidence qu’une simple alors une véritable prise de risque avec des conséquences
instruction comme une requête à destination d’un logiciel de parfois très critiques. Aussi, comme le souligne Philippe WERLE,
gestion de bases de données, quelques lignes de programmation les utilisateurs d’Internet doivent être conscients des dangers de
comme celles nécessaires à la création d’un logiciel malveillant la navigation sur le web, être vigilants (voire méfiants) et acquérir
(keylogger, Trojan Horses...) ou encore un rootkit peuvent le réflexe d’accorder leur confiance aux seuls certificats signés.
suffire à perpétrer des intrusions au sein d’applicatifs de notre Coté organismes administrant des serveurs web, une prise de
quotidien (site web), à récupérer/étendre des droits d’accès, conscience est également nécessaire pour abandonner les
à la récupération illicite de données (bases de données) ou à certificats auto-signés et, plus globalement, financer la sécurité
leur modification (perte d’intégrité) jusqu’à la prise de contrôle informatique à hauteur des menaces potentielles. Dans le cas
de systèmes (compromission). Certes, comme évoqué dans de l’enseignement supérieur recherche, Philippe WERLE précise
les échanges autour de cet exposé, il existe des solutions qu’il existe un marché public permettant d’obtenir sans frais des
techniques permettant de lutter contre ce type de failles : certificats. RENATER, notre réseau national de l’enseignement
application des mises à jour de sécurité des logiciels, inhibition supérieur recherche (NREN), bénéficie du contrat signé entre
du démarrage/boot de l’ordinateur à partir d’une clé USB, mise GEANT Association et le prestataire de certification commercial
en place de pare-feu, fermeture des ports de communication, Digicert (cf. https://www.renater.fr/certificats-tcs ).
etc. Néanmoins, comme souligné dans l’exposé et les débats,
l’être humain demeure le principal vecteur de vulnérabilité. Cette
vulnérabilité découle essentiellement de la méconnaissance
des risques et des mesures de protection, mais aussi des
caractéristiques psychologiques de l’individu cible (crédulité,
3 Uniform Resource Locator, couramment appelé « adresse web ».
4 Nous ne parlons pas ici de garantie de l’intégrité des données transmises mais bien de l’authenticité de la source de données.
RE V U E DE S DÉ PA RT E ME NT S D E GÉ N I E É L E C TR I QU E & I N F OR MATI QU E I N D USTRIELLE6 // ACTES DU COLLOQUE DE NÎMES
SCHNEIDER Electric : de chiffrement (Exemple : la vulnérabilité du chiffrement par
clé WEP dans les transmissions par réseau Wifi). Après une
Vulnérabilités et attaques des systèmes automatisés : présentation de la problématique liée la principale attaque
Les solutions Schneider pour limiter les risques logicielle dite de l’Homme au Milieu (Man in the middle), l’exposé
s’est ensuite concentré sur l’exploitation de cette technique de
Intervenant : Jimmy VABAGLIO - Schneider Electric
sécurisation des communications par chiffrement, pour la mise
Pour la plupart des individus, la sécurité informatique concerne en œuvre de cadres de travail à distance via des VPN (Réseaux
presque exclusivement les ordinateurs et les matériels de Privés Virtuels).
réseaux/communication. Cependant, depuis l’affaire du virus
Stuxnet qui s’est attaqué aux alimentations électroniques des
centrifugeuses nucléaires iraniennes5 via des SCADA6, une CISCO :
partie de la population a compris que les systèmes automatisés Sécurité dans les réseaux informatiques
de pilotage ou de supervision des systèmes de production Intervenant : Julien BERTON, France Technical Manager, Ile-
peuvent également être des cibles potentielles d’attaques. de-France Area Academy Manager - INLEA at CISCO
Ceci est d’autant plus vrai que les automates programmables
Nul n’est besoin de présenter CISCO comme acteur international
industriels, les systèmes de supervision et autres éléments de
majeur dans le domaine des réseaux informatiques. Basé sur
base des systèmes automatisés, sont de plus en plus dotés
l’Annual Cybersecurity Report (2018) de cette entreprise, l’exposé
de services/fonctionnalités logicielles pour s’intégrer dans des
de Monsieur Julien BERTON, Technical Manager chez INLEA at
environnements à haute connectivité. Selon des chiffres présentés
CISCO, a apporté un éclairage particulièrement instructif sur la
dans cet exposé, la vulnérabilité des Systèmes de Contrôle
quantification, à l’échelle internationale, de la menace inhérente
Commande est bien réelle avec, par exemple, une multiplication
à la propagation d’attaques via les réseaux informatiques. La
par 10 environ du nombre de failles découvertes sur des produits
principale contribution à cette menace est actuellement celle
industriels entre 2010 et 2012. Ceci découle essentiellement
des ransomware. Or, comme présenté dans cet exposé, que
d’une prise en compte insuffisante des risques (induisant un
ce soit à partir de la consultation de sites web, de la réception
manque de sécurisation des produits) par les différents acteurs :
de mails ou autres, les infections par ransomware résultent,
constructeurs, éditeurs, intégrateurs, utilisateurs, etc. Or, comme
avant tout, d’une « erreur » humaine : click sur un lien vers un
souligné par Monsieur Jimmy VABAGLIO, spécialiste sécurité
site diffusant des logiciels malveillants (malvertising), lecture
chez Schneider Electric, une seule défaillance dans un des
d’une pièce jointe infectée, etc. Si les vecteurs de propagation
maillons de cette chaine d’acteurs suffit à anéantir la sécurité du
sont les supports de stockage amovibles (clés USB, DVD) et la
système complet. Ceci suppose donc, non seulement de définir
connexion à Internet, l’individu reste donc la principale source de
une stratégie globale de cybersécurité mais aussi d’accompagner
vulnérabilité. Comme déjà évoqué dans d’autres exposés, cette
l’ensemble des acteurs dans la mise en œuvre de cette stratégie.
vulnérabilité découle du manque de connaissance des risques,
Cet exposé a donc présenté l’expertise de Schneider Electric
de l’omission volontaire ou non des mises à jour de protection
en matière de cybersécurité, de méthodologie de mise en place
contre les menaces connues, du non-respect des procédures et
d’une cybersécurité industrielle et d’accompagnement des
règles de mise en sécurité des systèmes, etc. L’acquisition de
acteurs (formation, aide à la rédaction de cahier des charges,
ces connaissances et de ces reflexes passe, avant tout, par la
rédaction de politique de sécurité ...). Cet exposé a également
formation. La seconde partie de cet exposé a donc concerné
permis d’aborder le durcissement des équipements de la marque
différentes offres de formations dispensées par CISCO, en
Schneider (remplacement des protocoles non-sécurisés par leurs
matière de sécurité des réseaux et de cybersécurité. Ces
homologues sécurisés, l’activation des fonctions de sécurité
formations, telles que Cybersecurity Essentials, CCNA Security...
embarquées ...) et les perspectives de développement de ce
(voir : https://www.netacad.com/fr/courses/), sont accessibles
durcissement (sécurisation des communications, renforcement
aux enseignants et/ou aux étudiants via différentes formes de
du contrôle d’accès logique...).
partenariats, et permettent notamment d’obtenir des niveaux de
certifications reconnus, tant au niveau national qu’international.
Communications sécurisées – VPN :
Confidentialité / intégrité des données transmises
Intervenant : Joël DURAND - IUT de Nîmes Attaques matérielles :
Comme déjà évoqué, une des principales problématiques en Principales attaques (canaux cachés, fautes…),
matière de sécurité informatique concerne la transmission
des données. Que ce soient la communication de données confiance dans les circuits intégrés (chevaux de troie)
personnelles telles que les informations relatives à une carte bleue Intervenant : Florent BRUGUIER - IUT de Nîmes
lors d’un paiement via Internet ou des données professionnelles Après plusieurs exposés sur les attaques logicielles dans les
sensibles (fichier client d’un agent commercial). L’objectif est de systèmes informatisés, les systèmes d’automatismes, les
préserver à la fois la confidentialité (non-divulgation) et l’intégrité matériels de communication / réseau, l’exposé de Florent
(non-altération ou non transformation par un tiers) des données BRUGUIER a permis d’aborder une catégorie d’attaques encore
transmises. Le problème est d’autant plus complexe que les peu connue du grand public et qui concerne directement les
informations circulent, la plupart du temps, via l’intermédiaire composants électroniques (circuits intégrés). À titre d’exemple,
de réseaux publics. Une solution connue depuis l’antiquité est Florent BRUGUIER a présenté deux techniques de cassage de
naturellement de chiffrer7 les données. Cet exposé a donc été clés de chiffrement basées sur l’observation, respectivement,
l’occasion de rappeler/présenter le principe des méthodes de de la consommation d’énergie ou du temps de réaction des
chiffrements par clés publiques et privées, asymétriques vs composants impliqués dans l’authentification des clés. De
symétriques, et de discuter de la fiabilité de certaines méthodes manière vulgarisée : Pour pouvoir comparer une clé transmise
5 1/3 du parc des centrifugeuses servant à l’enrichissement de l’uranium ont été détruites.
6 Supervisory Control And Data Acquisition (Système de contrôle et d'acquisition de données).
7 Le chiffrement est le procédé avec lequel on rend la compréhension d’un document impossible à toute personne qui n’a pas la clé de déchiffrement.
GESI // 37 e ANNÉEN°92 // DÉCEMBRE 2018 // ACTES DU COLLOQUE DE NÎMES / 7
avec la vraie clé de chiffrement, il faut que cette dernière soit ainsi que des éléments de cours sur la sécurité des réseaux, des
chargée dans une mémoire. La zone de mémoire concernée systèmes d’exploitation et dans le cadre du développement de
subit donc des transitions de l’état bas à l’état haut et vice logiciels. Comme souligné par Philippe WERLE, Vice-Président
et versa, afin de matérialiser les états logiques 0 et 1. Or, ces Outils CyberEdu, les fiches de cette mallette s’adressent à un
transitions d’états ne consomment pas la même énergie (et large public et sont telles que l’acquisition de compétences (en
ne correspondent pas aux mêmes temps de transitions). En auto-formation) et l’exploitation de ces outils pédagogiques ne
observant « cellule par cellule » les consommations d’énergies sont pas réservées aux seuls enseignants techniques. De plus,
(ou les temps de transition), il est alors possible d’en déduire ces fiches balayent un spectre étendu de sujets/compétences
la clé de chiffrement. Au-delà de ces aspects techniques, cet : de la sensibilisation et initiation à la Cybersécurité à des
exposé a alors soulevé une importante question relative à la aspects plus pointus comme la sécurité dans les composants
confiance que l’on peut accorder aux composants achetés électroniques. Enfin, signalons que la contribution de CyberEdu
auprès de certains fabricants. Autrement dit, quelle garantie ne s’arrête pas à ce kit pédagogique puisqu’elle organise
a-t-on que le circuit intégré que nous implantons sur notre également des colloques à travers la France et vise à délivrer
carte électronique ne cache pas un émetteur / « transmetteur un label CyberEdu aux formations (et donc aux étudiants)
» d’informations, un système de blocage du fonctionnement ou référencées comme intégrant des contenus de sensibilisation à
autre ? Là encore, une sensibilisation des étudiants de GEII à ce la sécurité informatique (pour plus d’informations : http://www.
genre de risques apparait comme très importante en vue de leur cyberedu.fr/).
insertion dans les secteurs industriels de l’électronique et des
systèmes embarqués. Conclusion
Les différents exposés ont permis de mettre en exergue de
CyberEdu nombreuses menaces, de nombreuses techniques d’attaques
(http://www.cyberedu.fr/) CyberEdu et une pluralité des cibles matérielles (de l’ordinateur à l’objet
Association et labellisation connecté en passant par les composants d’automatismes). Au-
delà de la sophistication technique des attaques, le principal
Intervenant : Philippe WERLE - Vice-Président Outils vecteur de vulnérabilité demeure l’être humain lui-même. La
CyberEdu - Responsable du Management de la Sécurité des connaissance des risques et des méthodes de protection
Systèmes d'Information (Université de Bordeaux) demeure donc la meilleure solution pour développer la sécurité
Au regard des différents exposés, il est clairement apparu que informatique et contrecarrer la cybercriminalité. Il semble donc
la formation était un élément clé de la lutte contre les différentes important pour nous, enseignants de toutes matières, d’acquérir
formes d’attaques informatiques (incluant les cyberattaques). des compétences en cybersécurité / sécurité des systèmes
Dans ce sens, l’objectif de l’association CyberEdu, soutenue informatiques afin de sensibiliser ou, encore mieux, de former
par l’ANSSI (Agence Nationale de la Sécurité des Systèmes nos étudiants aux risques et menaces, ainsi qu’à l’adoption de
d’Information), est d’inciter et d’accompagner l’intégration de bonnes pratiques.
la Sécurité des Systèmes Informatiques dans les formations
de l’enseignement supérieur. Pour cela, CyberEdu met à la
disposition des enseignants une mallette pédagogique contenant Remerciements : Je tiens à remercier Philippe Werle et Chantal
notamment : un guide pédagogique, un cours préparé d’environ 24 Faye pour leur relecture de cet article, ainsi que tous les
heures sur l’enseignement des bases de la sécurité informatique, intervenants de cette commission cybersécurité.
Arènes de Nîmes
RE V U E DE S DÉ PA RT E ME NT S D E GÉ N I E É L E C TR I QU E & I N F OR MATI QU E I N D USTRIELLE8 // ACTES DU COLLOQUE DE NÎMES
Commission 2
Énergie et efficacité
énergétique
Marouane ALMA (IUT de Longwy)
Alain TINEL (IUT du Havre)
L’épuisement à terme des ressources fossiles et Intervention de Mr Pascal Tigreat
fissiles et leur impact négatif sur l’environnement
impose une application généralisée de l’efficacité de la société Wago :
énergétique afin de maitriser la consommation « Présentation des consommations
d’énergie tout en augmentant les sources dans un bâtiment smart »
renouvelables. Le bâtiment « smart » ou intelligent se définit comme un bâtiment à
Cette efficacité énergétique représente le rendement énergétique haute efficacité énergétique, intégrant dans sa gestion intelligente
complet d'un système : elle va donc dépendre de l'objectif du les équipements consommateurs, les équipements producteurs
système. Elle découle du rendement, mais est fonction de ce à et les équipements de stockage, tels que les véhicules électriques.
quoi l'énergie doit servir. La réglementation thermique RT 2012 impose de connaitre
Le secteur du bâtiment est, parmi les secteurs économiques, donc de mesurer la consommation en énergie et pour cela il faut
le plus gros consommateur en énergie. Il représente plus de repérer les différentes sources de consommation que peuvent
44% des consommations énergétiques nationales et près de être le chauffage, la climatisation, la ventilation, l’eau, l’éclairage
20% des émissions de CO2. La France s’est engagée très tôt et les équipements.
pour améliorer la performance énergétique des bâtiments et Dans un premier temps il convient de mesurer ces consommations
s’est dotée d’une réglementation thermique dès 1974, renforcée et cela peut se faire à postériori avec les factures ou par le relevé
régulièrement depuis. Le gouvernement français a décidé en des compteurs en place.
2007 le lancement d’une large concertation désormais connue
sous le nom de « Grenelle de l’environnement », qui a permis • Identification des postes de consommations :
d’amorcer la transition écologique de la France. -E lectricité : luminaires, centrale de traitement d’air, ventilation
mécanique centralisée, pompes, moteurs, groupe froid,
Les lois Grenelle ont ainsi servi de base pour définir la pompes à chaleur, ventilo-convecteur, ballon d’eau chaude
politique énergétique de la France, et notamment les principes sanitaire, serveurs, PC, etc.
de la nouvelle réglementation thermique. Cette nouvelle - Eau : points de livraison (robinet, douches, WC), points de
réglementation, appelée « RT 2012 » vise à généraliser le consommation.
Bâtiment Basse Consommation dans la construction neuve. - Gaz : chauffage, four, eau chaude sanitaire, laboratoire.
Les objectifs de cette commission ont été dans un premier
temps de sensibiliser le public, de présenter quelques solutions • Synthétisation des données :
de production d’énergie issues de sources renouvelables et - Base de données : simulation des consommations en fonction
leurs introductions dans l’enseignement GEII. Dans un deuxième des usages, des zones du bâtiment, de l’utilisation horaire des
temps des solutions technologiques de smartgrids nous ont été équipements (détection éventuelle de fuites).
proposées ainsi que leurs déclinaisons pour l’enseignement en • Identification des éléments énergivores :
DUT ou en LP. -Centrale de traitement d’air, chauffage électrique,
Des retours d’expériences pédagogiques sur ces thématiques compresseur…, la consommation due à l’éclairage peut être
nous ont également été rapportés. importante en fonction de la vétusté du matériel (si utilisation
d’un ballast électronique gain de 20 à 30% et si utilisation de
led cela implique un gain de 50 à 60%)
- Mesurer sur chaque départ la consommation réelle et pour les
gros postes faire un enregistrement régulier de la consommation
journalière et hebdomadaire
GESI // 37 e ANNÉEN°92 // DÉCEMBRE 2018 // ACTES DU COLLOQUE DE NÎMES / 9
- Analyser les consommations : L’exemple présenté concerne le système Pelton-3E - Microcentrale
- Proposer des améliorations (gestion de plages horaires, hydroélectrique Tri-Énergie. Pour assurer l’optimisation de la
anticipation) gestion de l’énergie, Smartgrid, ce banc permet de contextualiser
- Proposer des changements (équipements, principe de la transition énergétique d’une centrale thermique vers un mixte
fonctionnement) énergétique à base d’énergies renouvelables : éolien, solaire et
- Voir si les abonnements sont bien dimensionnés hydro électrique.
- Adaptation de la consommation : Ce dispositif donne la possibilité d’aborder et d’étudier les
- en fonction de la tarification ou équilibrage réseau, différents thèmes suivants :
- avec des compteurs communicants, Energie : produire de l’électricité
- en décalant sa consommation (load shifting), • Energie hydraulique, chute d’eau
- en effaçant sa consommation (production autonome), • Energie fluidique, éolienne
- Agrégateur (engagement d’un groupe d’entreprises de ne pas • Energie solaire, photovoltaïque
consommer en même temps et suivant certaines plages horaires) Stocker l’électricité
• Le grid (équilibrage du réseau) : il faut que la consommation du • Energie potentielle, eau de retenue
réseau soit équilibrée avec la production. • Energie mécanique, volant d’inertie
- Stockage de l’énergie (chaleur, ballon d’eau chaude, frigo) • Chimique, batterie
- Stockage de l’électricité (alimentation sans interruption (UPS), Transporter et gérer l’énergie électrique
batteries ou véhicule électrique) • Structure d’un réseau de transport
La société Wago propose entre autres des produits orientés • Pertes dues au transport
efficacité énergétique. • Gérer les besoins de 4 consommateurs (Usine, Habitat, Hôpital,
Pompage) en fonction des énergies disponibles
Intervention de Mme Claire Basset Matière & structure : Etude de la turbine
• Choix d’un matériau en fonction des contraintes
de l’IUT de Ville d’Avray : • Prototypage (impression 3D)
« retour d’expérience sur la gestion d’éclairage » Information
• Acquérir : Capteurs de pression, Débitmètre
Dans le cadre du Concours Usage et Bâtiment Efficace (CUBE • Traiter : Automate Siemens
2020 : https://cube2020.org/ ) auquel l’IUT de ville d’Avray • Communiquer les informations : Réseau Ethernet
participe, le service patrimoine de cet IUT mène une réflexion • Gérer la consommation et la production « smartgrid »
globale sur sa consommation d’énergie. L’objectif du projet est
de mettre en œuvre des automatismes permettant de réduire
la consommation d’énergie dans une salle témoin (atelier
d’automatisme) qui permet de faire des mesures, de sensibiliser Intervention de Mr Samuel Nguefeu
les étudiants et de communiquer lors des journées portes
ouvertes. de R&D RTE :
Dans l’atelier d’automatisme d’une superficie de 60m2, il y a « Le futur de la distribution électrique et retour
eu modification de l’éclairage pour passer en technologie LED d’expérience Valise Soleis »
avec pilotage intelligent par bus DALI, il y a eu modification En première partie, Mr Nguefeu nous a parlé des aspects
du chauffage en intégrant une vanne 3 voies commandée en conventionnels des réseaux électriques, de la victoire du courant
fonction de l’occupation de la salle et il y a eu création d’une alternatif sur le courant continu :
supervision. Les mesures de puissance sont obtenues à partir
de 3 centrales de mesure connectées en réseau, le chauffage • Transformation facile des niveaux de tension pour réduire les
est géré par un automate programmable industriel qui prend pertes de transport.
en compte la consigne de température et l’état ouvert ou fermé • Evolution facile de la structure du réseau
des fenêtres. L’éclairage est pris en charge par un automate •
Elimination facile des tronçons de réseaux en défaut
programmable industriel WAGO et une interface DALI. Ce projet (disjoncteurs)
est entré dans le cadre des projets tuteurés pour 10 étudiants de Les missions de RTE sont de développer, exploiter et maintenir
DUT en 2015/2016, 4 étudiants en 2016/2017 et 2 étudiants de le réseau de distribution.
DUT et 2 de LP en 2017/2018.
Les perspectives sont d’obtenir des données de commande pour
le chauffage en fonction de la météo et de l’emploi du temps, La deuxième partie concerne l’avènement des énergies
d’avoir un affichage en temps réel de la consommation électrique, renouvelables :
de créer une page web et d’étudier la cybersécurité du système. •Photovoltaïque, Thermique, Eolien, Hydraulique, Biomasse,
Géothermie.
Intervention de Mr Claude Bouchard En 2018, les énergies renouvelables ont couvert 22,8% de la
consommation d’électricité en France.
de la société ACE Didactique Le stockage de l’énergie électrique :
•
Les Stations de Transfert d'Energie par Pompage (STEP)
La société ACE Didactique est composée de 3 départements :
permettent d'éviter le gaspillage d'énergie pendant les heures
- Energies et environnement
creuses (nuit, week-end) et de pallier à l'intermittence de la
- Industries
production électrique du secteur éolien et solaire.
- Technologie
• Le projet RINGO (ligne virtuelle) : l'entreprise veut "construire le
Leurs buts sont les :
premier réseau qui conjugue électricité et digital". L'objectif est
- Développement de petites parties opératives pour l’éducation
de répondre aux évolutions rapides des usages de l'électricité
-Développement de scénarios pour développer des
(arrivée des véhicules électriques et bâtiments intelligents,
automatismes
notamment) et à la multiplication des acteurs (nouveaux
RE V U E DE S DÉ PA RT E ME NT S D E GÉ N I E É L E C TR I QU E & I N F OR MATI QU E I N D USTRIELLE10 // ACTES DU COLLOQUE DE NÎMES
producteurs, agrégateurs, opérateurs d'effacement, etc.). Pour distribution ou fonctionner en mode îloté. Le concept est en train
y parvenir, l'entreprise entend privilégier des solutions "légères" de s’élargir aux réseaux de chaleur et de gaz. Le concept de
dont les lignes virtuelles qui visent à renforcer le réseau sans microgrids peut ainsi être pensé de façon multi-fluides et il peut
créer de nouvelles lignes. Des batteries rendraient le même concerner différentes échelles du territoire (bâtiment, quartier,
service que celui fourni par un renforcement des lignes saturées zone industrielle ou artisanale, village, etc.).
ou la création de nouvelles lignes physiques.
Bilan prévisionnel de RTE : Intervention de Mr Di Pillo de l’IUT
•Augmentation des énergies renouvelables
• Fermeture des réacteurs nucléaires
de Longwy :
• Evolution de la consommation « Retour d’expérience sur le Cyclo-grid de schneider »
• Augmentation du nombre de véhicule électrique. L’efficacité énergétique a été introduite pour assurer une
Convergence des technologies de l’énergie électrique et du optimisation de l’utilisation de l’énergie tout en fournissant les
numérique (courant porteur en ligne, fibre optique). mêmes services. Elle est définie par le rapport entre l’énergie
Cybersécurité (IEC 61850) : les équipements de postes sont fournie et l’énergie consommée. Ces enjeux ont été présentés
dotés d’une interface numérique leurs permettant de dialoguer pour 3 secteurs importants : Le bâtiment (RT2012), l’industrie
avec les contrôle-commandes numériques : disjoncteurs, (Norme CEI 60034-30-1) et le transport (Norme NF EN 16247-
sectionneurs, interrupteurs, transformateur de puissance. 4). M. Di Pillo a défini les Smartgrids et leur contribution dans
Concernant la valise Soleis présentée, celle-ci est utilisée en l’efficacité énergétique par l’adaptation de la distribution de
TP avec les étudiants de l’IUT de Villetanneuse. Elle permet de l’énergie électrique, depuis sa production, en fonction de la
faire des branchements et de calculer la puissance de panneaux demande, avec comme intérêt l’équilibrage entre la production
photovoltaïques. Le logiciel AGS permet lui de récupérer les et la demande.
données et de tracer les courbes de puissances en fonction de
l’inclinaison essentiellement.
Intervention de Mr Gonzales
de Schneider Electric :
« les smartgrids »
Pour faire face aux mutations du paysage énergétique, il est Image : Olivier Di Pillo – IUT de Longwy
nécessaire de moderniser le système électrique. Le contexte
français et européen, dans lequel se sont développés les réseaux Avantages des smartgrids :
électriques, conduit à privilégier le déploiement des technologies - Pour le client : offres de services diversifiées et réduction des
de Smartgrids plutôt que le remplacement et le renforcement délais de prestations.
massif des réseaux. - Pour le producteur : intégration de sources d’énergie décentra-
L’intégration des nouvelles technologies de l’information et de lisées, insertion de sources de stockage et possibilités de gérer
la communication aux réseaux les rendra communicants et de nouveaux usages avec maintenance et suivi simplifiés des
permettra de prendre en compte les actions des acteurs du sites décentralisés (gain économique).
système électrique, tout en assurant une livraison d’électricité - Pour le fournisseur : pas de déplacement sur site (intervention
plus efficace, économiquement viable et sûre. ou relevé) et pilotage à distance.
Les grands principes des smartgrids sont :
- Supervision et contrôle : transport, état du réseau, mesure et
comptage,
- Optimisation : reconfiguration du réseau et gestion de la
demande,
- Anticipation : maintenance et gestion prévisionnelle du stockage
de l’énergie.
Le système électrique sera ainsi piloté de manière plus flexible
pour gérer les contraintes telles que l’intermittence des énergies
renouvelables et le développement de nouveaux usages tels que
le véhicule électrique. Ces contraintes auront également pour
effet de faire évoluer le système actuel, où l’équilibre en temps
réel est assuré en adaptant la production à la consommation, vers
un système où l’ajustement se fera davantage par la demande,
faisant ainsi du consommateur un véritable acteur. Image : Olivier Di Pillo – IUT de Longwy
Les microgrids, appelé aussi mini smartgrids ou micro-
réseaux intelligents, sont des réseaux électriques de petite Par la suite, le dispositif Cyclo-grid de Schneider a été présenté
taille, conçus pour optimiser la facture énergétique, fournir un en détail avec ses chaines d’information et d’énergie, la possibili-
approvisionnement électrique fiable (surmonter les blackouts) té d’inclure différentes sources d’énergie (éolien, photovoltaïque,
et de meilleure qualité à un petit nombre de consommateurs. stockage batterie ou réseau EDF), ainsi que les différents profils
Ils agrègent de multiples installations de production locales et d’utilisation possibles (privilégier l’utilisation d’une source au dé-
diffuses (micro-turbines, piles à combustible, petits générateurs triment de la disponibilité de l’énergie ou l’inverse).
diesel, panneaux photovoltaïques, mini-éoliennes, petite L’utilisation du dispositif Cyclo-grid en travaux pratiques de DUT
hydraulique), des installations de consommation, des installations GEII ou en LP dans les différentes matières liées à l’énergie (au-
de stockage et des outils de supervision et de gestion de la tomatisme, réseaux locaux industriels, convertisseurs), a été pré-
demande. Ils peuvent être raccordés directement au réseau de sentée en fin d’exposé.
GESI // 37 e ANNÉEVous pouvez aussi lire